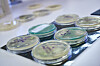

UTVALGTE STILLINGER:
-
Postdoktor innen tverrfaglig prosjekt om endringer i norsk straffegjennomføring
Søknadsfrist: 05.06.2026
-
Seniorforskere
Søknadsfrist: 01.06.2026
-
Doktorgradsstipendiat (ph.d.) i samarbeid med CICERO
Søknadsfristem: 10.06.2026
-
Researcher Position in Precision Medicine and Monogenic Diabetes
Deadline: 07.06.2026
-
Forskningssjef - klimasmart og bærekraftig skogbruk
Søknadsfrist: 07.06.2026
-
PhD Research Fellowship: Exploring how prison affects prisoners health and wellbeing
Deadline: 04.06.2026
-
PhD Fellowship in Communication and Leadership
Deadline: 01.06.2026
-
Professor / førsteamanuensis i regnskap og bedriftsøkonomiske fag
Søknadsfrist: 31.05.2026
-
Førsteamanuensis / førstelektor innen regnskap og bedriftsøkonomiske fag
Søknadsfrist: 31.05.2026